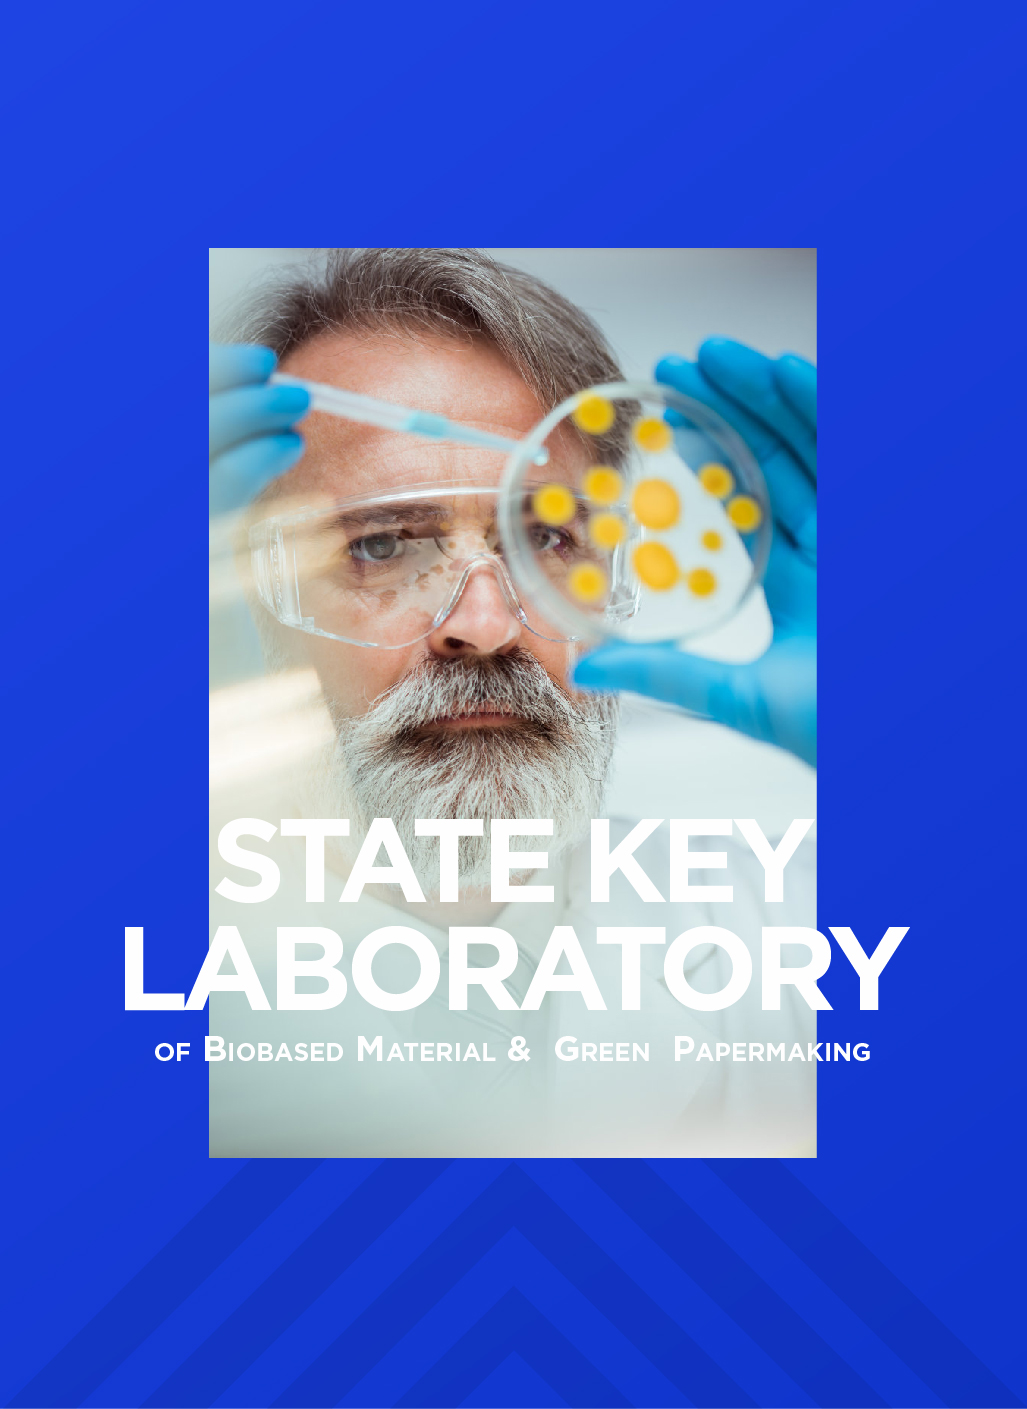
齊魯工業大學生物基材料與綠色造紙國家重點

-

結合企業品牌定位,行業特點和人群屬性,制定并執行數字營銷策略。

網站設計,網站升級,網站改版

品牌營銷型外貿網站,打造激光工業應用領域高端品牌外貿網站,加快品牌出海營銷之路。

網站設計,高端品牌網站建設,打造建筑設計行業高端品牌網站,開啟品牌營銷之路。

高端網站設計策劃 · 電力系統數字化高端網站建設,集企業數字營銷與品牌運營為一體

網站設計 - 功能網站定制開發 · 物流系統網站建設,響應數字營銷號召,打造企業品牌營銷窗口

高端品牌官網建設,濟南高端網站建設公司打造全球化軟家具行業高端網站典范

靜電噴霧消毒設備行業高端網站建設 · 杰瑞華創品牌官網建設

外貿高端網站建設 · 品牌國際站官網建設 · 數字營銷品牌國際化
高端網站建設 · 齊魯工業大學品牌官網建設

高端網站設計 · 海洋裝備行業高端品牌官網建設

數字化車間高端網站建設 · 工業物聯網行業高端品牌官網建設

數據管理平臺H5開發,志愿者服務項目策劃、設計、開發、運營、小程序開發

官網設計策劃,專業海外生活服務機構高端品牌網站建設

平臺策劃 設計開發 中國檢科院跨境食品品質與質量控制數據平臺高端功能網站建設